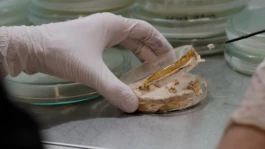
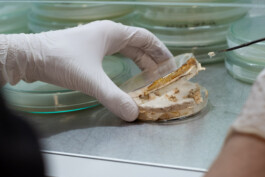

Wir revolutionieren die Raumakustik und Wärmedämmung mit einem bemerkenswerten Naturmaterial: Pilzmyzel. Mit dieser natürlichen Lösung bieten wir eine überlegene Akustik und effiziente Dämmung, die gegenüber herkömmlichen Materialien viele Vorteile bringt.
Unser Ziel ist es, synthetische Materialien wie Kunststoff durch biologisch abbaubare Kompositmaterialien zu ersetzen. Mit kreislaufbasierten Lösungen bekämpfen wir die globale Ressourcenkrise und gestalten eine umweltfreundlichere Zukunft. Gleichzeitig schaffen wir gesündere Wohn- und Arbeitsumgebungen.
Unsere Paneele werden nicht gebaut oder zusammengeklebt – wir lassen sie wachsen! Dabei machen wir uns eine faszinierende Eigenschaft von Pilzen zunutze. Pilzmyzel, das Netzwerk aus feinen Pilzfäden, wächst unter der Erde oder in anderen Substraten und dient dem Pilz zur Nahrungsaufnahme. In unseren Paneelen fungiert das Myzel als natürlicher "Klebstoff", der die verschiedenen natürlichen Komponenten verbindet – ganz ohne künstliche und umweltschädliche Substanzen.
Mit Mycolutions haben wir einen standardisierten Produktionsprozess für unsere modularen Absorberplatten etabliert. Darüber hinaus ermöglicht die Verwendung von 3D-geformten Inlays in den Wachstumsformen eine breite Palette von Oberflächenstrukturen, ohne den Herstellungsprozess zu verändern.
Das Ergebnis sind 100% natürliche und schadstofffreie Schallabsorber und Dämmmaterialien, die von Natur aus hervorragende Eigenschaften mitbringen.
100% BioZirkulär
wasser-sparend
co2 sparend
toxinfrei


SCHALLABSORBER AUS MYZEL
Unsere akustischen Absorber dämpfen Schall effektiv über einen breiten Frequenzbereich. Die offenporige Oberfläche des natürlichen Myzelmaterials reduziert Lärm durch die Umwandlung von Schallenergie und eignet sich somit ideal für Büros, Coworking Spaces, Studios oder andere Räume, in denen Hall eine Herausforderung darstellt. Zudem ermöglicht unser Herstellungsprozess eine Vielzahl von Oberflächenstrukturen, wodurch unsere Schallabsorber auch visuell Akzente setzen.
Wir arbeiten bereits intensiv an weiteren nachhaltigen Raumlösungen. Denn wir sind überzeugt: exzellente Akustik, ein gesundes Raumklima und Nachhaltigkeit gehen Hand in Hand.






Trader - Galerie und Café
Trader - Galerie und Café
Utopia Lüneburg - Gründungszentrum und Co Working
Utopia Lüneburg - Gründungszentrum und Co Working
Abstract Now - Klang-Installation
Abstract Now - Klang-Installation
Wir sind ein fünfköpfiges Team aus Umwelttechniker:innen und Produktdesigner:innen aus Hamburg, vereint durch unsere Begeisterung für natürliche Materialien und technische Lösungen. Unsere Leidenschaft für Musik und unser tiefes Verständnis für die Natur inspirieren uns täglich. Wir sind überzeugt, dass es nachhaltige Alternativen zu herkömmlichen Werkstoffen geben sollte – frei von Schadstoffen, bezahlbar und ressourcenschonend.
Wir sind uns sicher: Hier liegt – im wahrsten Sinne des Wortes – noch eine ganze Menge Wachstumspotenzial.


Process engineer
Dominik Berndt

Co-Founder & CEO
Helge Schritt

product design
Annina Spies

Co-Founder & CoO
Thies Lingner
Möchten Sie mehr über unsere Lösungen erfahren oder haben Sie Fragen zu unseren Produkten? Füllen Sie einfach das untenstehende Formular aus, und wir melden uns so schnell wie möglich bei Ihnen.
MycoLutions ist ein innovatives Unternehmen, das nachhaltige Akustik- und Dämmmaterialien aus Pilzmyzel entwickelt. Diese Materialien sind biogen, toxinfrei und vollständig biologisch abbaubar. Unsere Vision ist es, künftig umweltbelastende Materialien wie Styropor und synthetische Schäume durch Myzelmaterialien zu ersetzen, um so einen positiven Beitrag zur Reduzierung von Abfall und Umweltverschmutzung zu leisten und nachhaltige Lösungen für die Bau- und Innenraumgestaltung anzubieten.
Welche Vorteile bieten Myzelmaterialien im Vergleich zu herkömmlichen Materialien?
Myzelmaterialien zeichnen sich durch ihr geringes Gewicht und ihre einfache Handhabung aus und bieten darüber hinaus außergewöhnliche ästhetische und akustische Eigenschaften. Sie sind umweltfreundlich, da sie aus organischen Reststoffen hergestellt werden und am Ende ihres Lebenszyklus entweder recycelt oder kompostiert werden können.
Wie tragen Myzelmaterialien zur Nachhaltigkeit bei?
Durch die Verwendung von organischen Reststoffen aus der Landwirtschaft und die Möglichkeit der Kompostierung oder des Recyclings am Ende ihres Lebenszyklus tragen unsere Materialien zur Reduktion von Abfall und zum Schutz natürlicher Ressourcen bei.
Wie können Myzelmaterialien kompostiert werden?
Unsere Myzel-basierten Werkstoffe können ganz normal kompostiert werden.
Welche Maßnahmen ergreift MycoLutions zur Förderung der Nachhaltigkeit?
Bei MycoLutions setzen wir kontinuierlich ein Life Cycle Assessment (LCA) ein, um die Umweltbilanz unserer Produkte über ihren gesamten Lebenszyklus hinweg zu bewerten. Dieses Verfahren ermöglicht es uns, neue Lösungen und Technologien zu entwickeln, die unsere Produktionsprozesse optimieren und unseren ökologischen Fußabdruck minimieren.
Wie werden Myzelmaterialien hergestellt?
Unsere Materialien entstehen durch das Wachstum von Pilzmyzel auf organischen Reststoffen aus der Landwirtschaft. Das Myzel wirkt dabei als natürlicher Klebstoff, der die Komponenten ohne den Einsatz künstlicher oder umweltschädlicher Substanzen zu einer stabilen Matrix verbindet.
Welche Eigenschaften haben die Myzelmaterialien?
Unsere Paneele aus Myzelmaterial zeichnen sich durch ausgezeichnete Schallabsorption und effiziente thermische Isolation aus. Sie sind vielseitig einsetzbar und enthalten keine VOCs (flüchtige organische Verbindungen), die in herkömmlichen Baumaterialien, darunter Styropor, vorkommen und die Innenraumluftqualität beeinträchtigen können.
Wie kann ich Myzelmaterialien bestellen oder ein Projekt starten?
Kontaktieren Sie uns über das Formular auf unserer Website oder per E-Mail. Unser Team hilft Ihnen gerne bei der Auswahl der passenden Materialien und bei der Planung Ihres Projekts.
Bietet MycoLutions maßgeschneiderte Lösungen an?
Ja, wir bieten unter bestimmten Bedingungen auch maßgeschneiderte Lösungen an, die auf die spezifischen Bedürfnisse und Anforderungen Ihres Projekts zugeschnitten sind. Sprechen Sie direkt uns an, um mehr über die Möglichkeiten zu erfahren.
Was kosten die Module aus Pilzmyzel?
Die Preise für Module aus Pilzmyzel variieren je nach Umfang und Art der Bestellung. Daher können wir keine allgemeinen Preisangaben machen. Kontaktieren Sie uns und wir erstellen Ihnen gerne ein maßgeschneidertes Angebot für Ihr Projekt.
Für welche Anwendungsbereiche sind Myzelmaterialien geeignet?
Unsere Materialien sind ideal für Büros, Coworking Spaces, Studios und andere Räume, in denen Akustik und gesundes Raumklima wichtig sind. Sie können in der Architektur, Innenarchitektur und Designprojekten vielseitig eingesetzt werden.
Gibt es Beispiele für aktuelle Projekte?
Ja, wir haben bereits Pilotprojekte in Co-working Spaces und einer Kunstgalerie, die auch als Café genutzt wird. Diese Projekte demonstrieren die Vielseitigkeit und die ästhetischen Vorteile unserer Materialien.
Kann der Pilz in den Myzelmaterialien weiterwachsen?
Nein, nach dem Trocknungsprozess ist weiteres Wachstum des Pilzes unmöglich. Während der Herstellung wird das Material erhitzt und getrocknet, wodurch das Pilzwachstum dauerhaft gestoppt wird. Dadurch ist sichergestellt, dass der Pilz nicht weiterwächst.
Können die Myzelmaterialien Pilzsporen ausstoßen?
Nein, Myzelmaterialien geben keine Pilzsporen ab. Im Produktionsprozess sowie im fertigen Produkt werden keine Fruchtkörper gebildet, wodurch eine Sporenfreisetzung ausgeschlossen ist.
Wie widerstandsfähig sind Myzelmaterialien gegen Feuchtigkeit und Schimmel?
Unsere Paneele aus Pilzmyzel sind grundsätzlich widerstandsfähig und hydrophob. Dennoch empfehlen wir, sie nicht in feuchten Räumen wie Badezimmern oder im Außenbereich zu verwenden, da dies ihre Lebensdauer beeinträchtigen kann.
Wie lange halten Myzelmaterialien?
Bei konstanten Raumbedingungen haben unsere Myzelmaterialien eine geplante Lebensdauer von etwa 10 Jahren.
Unterstützt von:
Auszeichnungen und Zertifikate:









Dieses Projekt wird von der EIT-Gemeinschaft NEB unterstützt, einer Initiative des Europäischen Instituts für Innovation und Technologie (EIT), einer Einrichtung der Europäischen Union.

—
Wir revolutionieren die Raumakustik und Wärmedämmung mit einem bemerkenswerten Naturmaterial: Pilzmyzel. Mit dieser natürlichen Lösung bieten wir eine überlegene Akustik und effiziente Dämmung, die gegenüber herkömmlichen Materialien viele Vorteile bringt.
Unser Ziel ist es, synthetische Materialien wie Kunststoff durch biologisch abbaubare Kompositmaterialien zu ersetzen. Mit kreislaufbasierten Lösungen bekämpfen wir die globale Ressourcenkrise und gestalten eine umweltfreundlichere Zukunft. Gleichzeitig schaffen wir gesündere Wohn- und Arbeitsumgebungen.
Unsere Paneele werden nicht gebaut oder zusammengeklebt – wir lassen sie wachsen! Dabei machen wir uns eine faszinierende Eigenschaft von Pilzen zunutze. Pilzmyzel, das Netzwerk aus feinen Pilzfäden, wächst unter der Erde oder in anderen Substraten und dient dem Pilz zur Nahrungsaufnahme. In unseren Paneelen fungiert das Myzel als natürlicher "Klebstoff", der die verschiedenen natürlichen Komponenten verbindet – ganz ohne künstliche und umweltschädliche Substanzen.
100% BioZirkulär
wasser-sparend
co2 sparend
toxinfrei
SCHALLABSORBER AUS MYZEL
Unsere akustischen Absorber dämpfen Schall effektiv über einen breiten Frequenzbereich. Die offenporige Oberfläche des natürlichen Myzelmaterials reduziert Lärm durch die Umwandlung von Schallenergie und eignet sich somit ideal für Büros, Coworking Spaces, Studios oder andere Räume, in denen Hall eine Herausforderung darstellt. Zudem ermöglicht unser Herstellungsprozess eine Vielzahl von Oberflächenstrukturen, wodurch unsere Schallabsorber auch visuell Akzente setzen.
Wir arbeiten bereits intensiv an weiteren nachhaltigen Raumlösungen. Denn wir sind überzeugt: exzellente Akustik, ein gesundes Raumklima und Nachhaltigkeit gehen Hand in Hand.






Trader - Galerie und Café
Trader - Galerie und Café
Utopia Lüneburg - Gründungszentrum und Co Working
Utopia Lüneburg - Gründungszentrum und Co Working
Abstract Now - Klang-Installation
Abstract Now - Klang-Installation
Wir sind ein fünfköpfiges Team aus Umwelttechniker:innen und Produktdesigner:innen aus Hamburg, vereint durch unsere Begeisterung für natürliche Materialien und technische Lösungen. Unsere Leidenschaft für Musik und unser tiefes Verständnis für die Natur inspirieren uns täglich. Wir sind überzeugt, dass es nachhaltige Alternativen zu herkömmlichen Werkstoffen geben sollte – frei von Schadstoffen, bezahlbar und ressourcenschonend.
Wir sind uns sicher: Hier liegt – im wahrsten Sinne des Wortes – noch eine ganze Menge Wachstumspotenzial.


Process engineer
Dominik Berndt

Co-Founder & CEO
Helge Schritt

product design
Annina Spies

Co-Founder & CoO
Thies Lingner
Möchten Sie mehr über unsere Lösungen erfahren oder haben Sie Fragen zu unseren Produkten? Füllen Sie einfach das untenstehende Formular aus, und wir melden uns so schnell wie möglich bei Ihnen.
MycoLutions ist ein innovatives Unternehmen, das nachhaltige Akustik- und Dämmmaterialien aus Pilzmyzel entwickelt. Diese Materialien sind biogen, toxinfrei und vollständig biologisch abbaubar. Unsere Vision ist es, künftig umweltbelastende Materialien wie Styropor und synthetische Schäume durch Myzelmaterialien zu ersetzen, um so einen positiven Beitrag zur Reduzierung von Abfall und Umweltverschmutzung zu leisten und nachhaltige Lösungen für die Bau- und Innenraumgestaltung anzubieten.
Welche Vorteile bieten Myzelmaterialien im Vergleich zu herkömmlichen Materialien?
Myzelmaterialien zeichnen sich durch ihr geringes Gewicht und ihre einfache Handhabung aus und bieten darüber hinaus außergewöhnliche ästhetische und akustische Eigenschaften. Sie sind umweltfreundlich, da sie aus organischen Reststoffen hergestellt werden und am Ende ihres Lebenszyklus entweder recycelt oder kompostiert werden können.
Wie werden Myzelmaterialien hergestellt?
Unsere Materialien entstehen durch das Wachstum von Pilzmyzel auf organischen Reststoffen aus der Landwirtschaft. Das Myzel wirkt dabei als natürlicher Klebstoff, der die Komponenten ohne den Einsatz künstlicher oder umweltschädlicher Substanzen zu einer stabilen Matrix verbindet.
Welche Eigenschaften haben die Myzelmaterialien?
Unsere Paneele aus Myzelmaterial zeichnen sich durch ausgezeichnete Schallabsorption und effiziente thermische Isolation aus. Sie sind vielseitig einsetzbar und enthalten keine VOCs (flüchtige organische Verbindungen), die in herkömmlichen Baumaterialien, darunter Styropor, vorkommen und die Innenraumluftqualität beeinträchtigen können.
Für welche Anwendungsbereiche sind Myzelmaterialien geeignet?
Unsere Materialien sind ideal für Büros, Coworking Spaces, Studios und andere Räume, in denen Akustik und gesundes Raumklima wichtig sind. Sie können in der Architektur, Innenarchitektur und Designprojekten vielseitig eingesetzt werden.
Gibt es Beispiele für aktuelle Projekte?
Ja, wir haben bereits Pilotprojekte in Co-working Spaces und einer Kunstgalerie, die auch als Café genutzt wird. Diese Projekte demonstrieren die Vielseitigkeit und die ästhetischen Vorteile unserer Materialien.
Wie tragen Myzelmaterialien zur Nachhaltigkeit bei?
Durch die Verwendung von organischen Reststoffen aus der Landwirtschaft und die Möglichkeit der Kompostierung oder des Recyclings am Ende ihres Lebenszyklus tragen unsere Materialien zur Reduktion von Abfall und zum Schutz natürlicher Ressourcen bei.
Wie können Myzelmaterialien kompostiert werden?
Unsere Myzel-basierten Werkstoffe können ganz normal kompostiert werden.
Welche Maßnahmen ergreift MycoLutions zur Förderung der Nachhaltigkeit?
Bei MycoLutions setzen wir kontinuierlich ein Life Cycle Assessment (LCA) ein, um die Umweltbilanz unserer Produkte über ihren gesamten Lebenszyklus hinweg zu bewerten. Dieses Verfahren ermöglicht es uns, neue Lösungen und Technologien zu entwickeln, die unsere Produktionsprozesse optimieren und unseren ökologischen Fußabdruck minimieren.
Wie kann ich Myzelmaterialien bestellen oder ein Projekt starten?
Kontaktieren Sie uns über das Formular auf unserer Website oder per E-Mail. Unser Team hilft Ihnen gerne bei der Auswahl der passenden Materialien und bei der Planung Ihres Projekts.
Bietet MycoLutions maßgeschneiderte Lösungen an?
Ja, wir bieten unter bestimmten Bedingungen auch maßgeschneiderte Lösungen an, die auf die spezifischen Bedürfnisse und Anforderungen Ihres Projekts zugeschnitten sind. Sprechen Sie direkt uns an, um mehr über die Möglichkeiten zu erfahren.
Was kosten die Module aus Pilzmyzel?
Die Preise für Module aus Pilzmyzel variieren je nach Umfang und Art der Bestellung. Daher können wir keine allgemeinen Preisangaben machen. Kontaktieren Sie uns und wir erstellen Ihnen gerne ein maßgeschneidertes Angebot für Ihr Projekt.
Kann der Pilz in den Myzelmaterialien weiterwachsen?
Nein, nach dem Trocknungsprozess ist weiteres Wachstum des Pilzes unmöglich. Während der Herstellung wird das Material erhitzt und getrocknet, wodurch das Pilzwachstum dauerhaft gestoppt wird. Dadurch ist sichergestellt, dass der Pilz nicht weiterwächst.
Können die Myzelmaterialien Pilzsporen ausstoßen?
Nein, Myzelmaterialien geben keine Pilzsporen ab. Im Produktionsprozess sowie im fertigen Produkt werden keine Fruchtkörper gebildet, wodurch eine Sporenfreisetzung ausgeschlossen ist.
Wie widerstandsfähig sind Myzelmaterialien gegen Feuchtigkeit und Schimmel?
Unsere Paneele aus Pilzmyzel sind grundsätzlich widerstandsfähig und hydrophob. Dennoch empfehlen wir, sie nicht in feuchten Räumen wie Badezimmern oder im Außenbereich zu verwenden, da dies ihre Lebensdauer beeinträchtigen kann.
Wie lange halten Myzelmaterialien?
Bei konstanten Raumbedingungen haben unsere Myzelmaterialien eine geplante Lebensdauer von etwa 10 Jahren.
Unterstützt von:





Dieses Projekt wird von der EIT-Gemeinschaft NEB unterstützt, einer Initiative des Europäischen Instituts für Innovation und Technologie (EIT), einer Einrichtung der Europäischen Union.
Auszeichnungen und Zertifikate:



